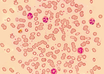

From Karnataka to Myanmar: 2 units of rare blood group saves woman
Partner Content | Dec 04, 2018
A first stem cell transplant after CAR T-cell therapy reduces relapses in ALL
American Society of Hematology Newsroom | Dec 04, 2018
STOI report points out bullying at NIMS; could have driven doctor suicide
Times of India | Dec 04, 2018
Two studies suggest Luspatercept reduces need for blood transfusions: ASH Annual Meeting
American Society of Hematology Newsroom | Dec 03, 2018
Ibrutinib outperforms chemoimmunotherapy in older patients with chronic lymphocytic leukemia: ASH Annual Meeting
American Society of Hematology Newsroom | Dec 03, 2018
Four cycles of chemotherapy as effective as six for diffuse large B-cell lymphoma: ASH Annual Meeting
American Society of Hematology Newsroom | Dec 03, 2018
First open heart surgery in UP under Ayushman Bharat project
IANS | Dec 03, 2018
Pregnancy is safe for breast cancer survivors: Experts
IANS | Dec 03, 2018
New self-powered sensor to monitor heart failure
IANS | Dec 03, 2018
Asean experts to meet on military medicine in Lucknow
IANS | Dec 03, 2018
Most read this week